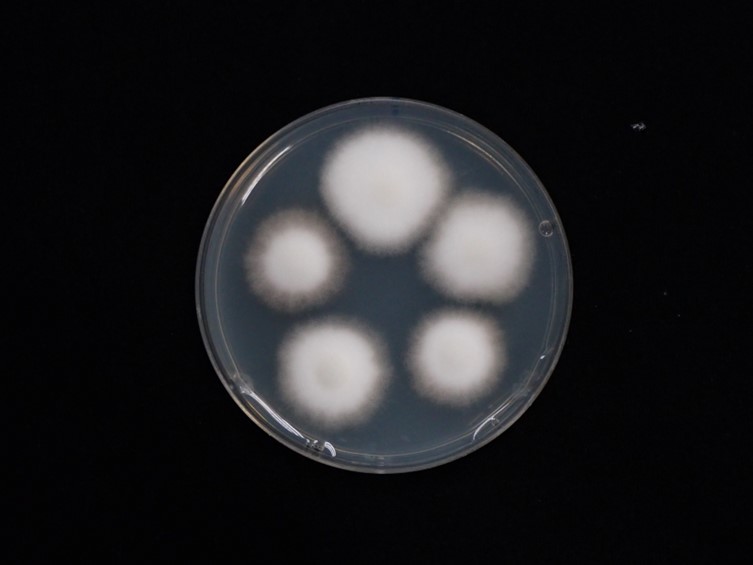

Holotype:
THAILAND, Nakhon Ratchasima Province, Khao Yai National Park, 31 May 2010, K. Tasanathai, P. Srikitikulchai, S. Mongkolsamrit, T. Chohmee, A. Khonsanit, R. Somnuk, K. Sansatchanon, holotype BBH 29656, ex-type living culture BCC 42062.
Habitat:
Underside of dicotyledonous leaves.
Host:
Spiders (Araneae; Thomisidae; Diaea cf. dorsata, Diaea sp.).
Description:










Host covered with yellowish-grey mycelium. 
Perithecia growing in subiculum, aggregated in clusters, superficial, ovoid, 650-850 × 250-320 μm, ostiole pale brown. 









Asci cylindrical, 8-spored, 375-460 μm long, 5-6 μm broad, with cap 2-6 μm thick.
Ascospores hyaline, whole ascospores with septate part-spores alternately connected with thread-like structures, four-terminal cells on each end with six alternating pairs of cells and filaments, sixteen cells per 








ascospore, up to 400 μm long, each cell narrowly fusiform, 10-15 × 1-2 μm, filiform regions, 35-45 × 0.2-0.8 μm.
Asexual morph: Two types of synnemata were produced from all parts of the hosts. Several
long synnema, grey becoming pale brown at terminal ends, cylindrical with blunt end, 2.5-5 mm long, 100-150 μm broad, middle of
long synnemata, 50-80 μm broad. Conidiogenous cells producing along long synnemata.
Short synnema, pale grey to dark grey, cylindrical, up to 450 μm long, 20-50 μm broad. Conidiogenous cells producing at the upper part of synnemata.
Phialides flask-shaped at the base, 5-10 × 3-5 μm, tapering into distinct necks, 2-3.5 × 0.5-1 μm. 









Conidia hyaline, fusiform, 3-6 × 1-2 μm.
Culture characteristics:

Colonies on PDA attaining a diam of 16–20 mm in 21 d, cottony with high mycelium density, white, reverse pale yellow. Conidia and reproductive structures not observed.
Reference:
Mongkolsamrit S, Noisripoom W, Tasanathai K, et al. (2022). Comprehensive treatise of Hevansia and three new genera Jenniferia, Parahevansia and Polystromomyces on spiders in Cordycipitaceae from Thailand. MycoKeys 91: 113–149.
DOI: https://doi.org/10.3897/mycokeys.91.83091Species |
Strain |
Compound |
Pubchem CID |
Biological activity |
Reference |
|---|
|
Strain |
ITS | LSU | RPB1 | RPB2 | TEF1 |
|---|---|---|---|---|---|
| BCC 42062 | MZ684091 | MZ684006 | MZ707828 | MZ707837 | MZ707815 |
| BCC 42063 | MZ684092 | MZ684007 | MZ707829 | MZ707838 | MZ707816 |
| BCC 54893 | MZ684093 | MZ684008 | - | MZ707839 | MZ707817 |
| BCC 57821 | MZ684094 | MZ684009 | - | MZ707840 | MZ707818 |